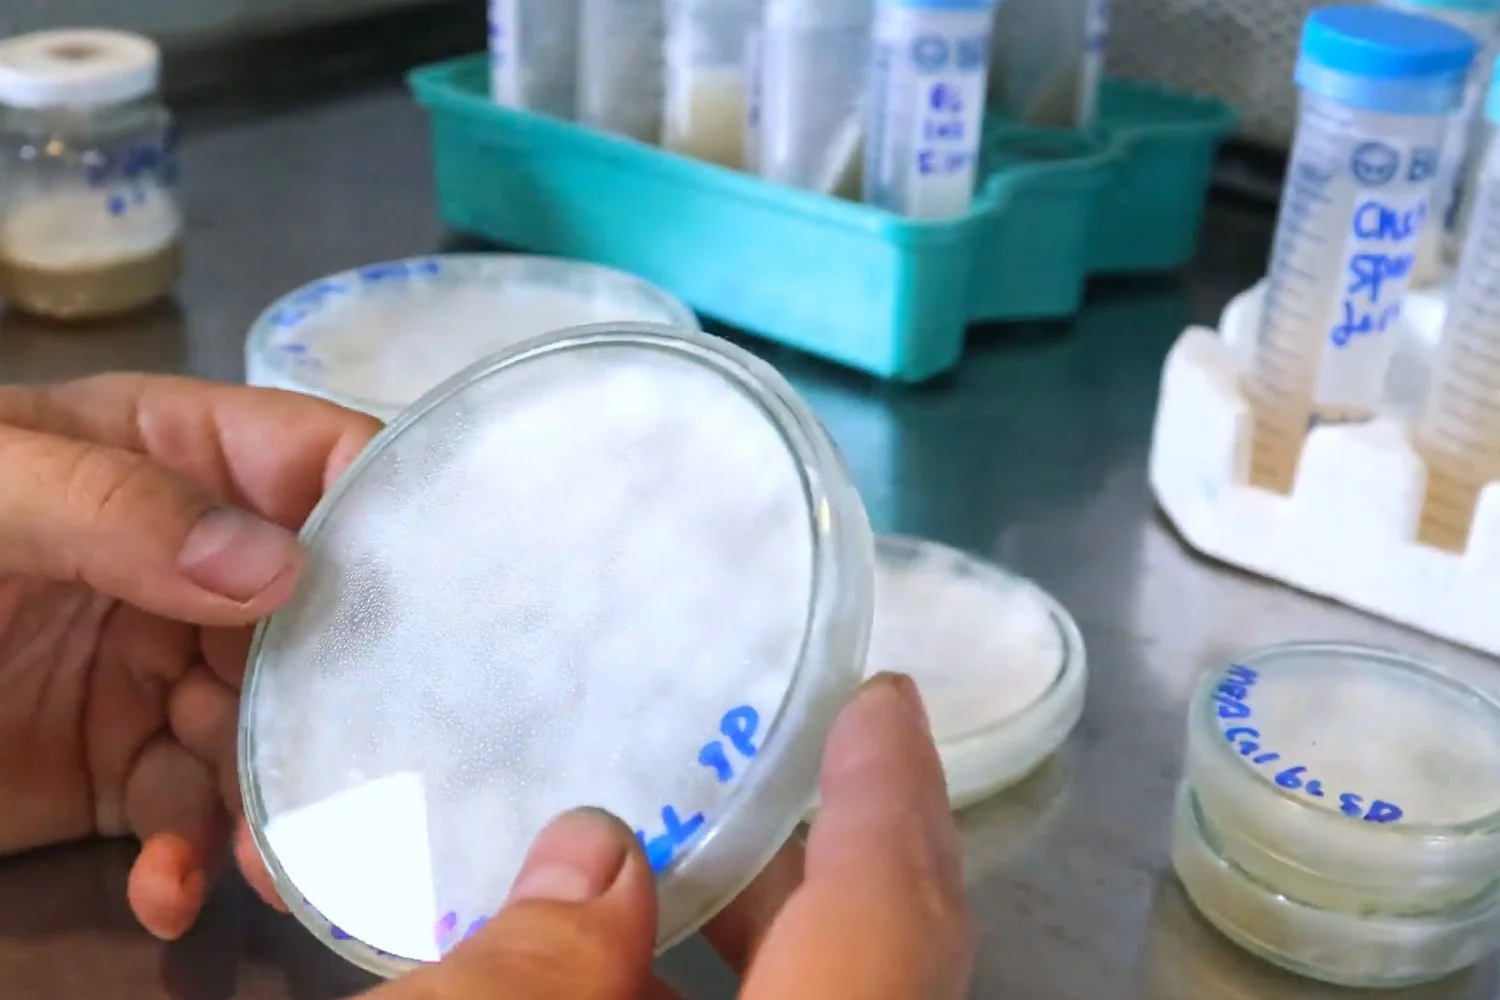
Control analítico de agua en laboratorio para pH y conductividad

Paso 01
Selección de genética
Cada ciclo inicia con material genético identificado y trazable. No abrimos lotes sin origen documentado ni criterios técnicos de arranque.

- Origen documentado
- Identificación de cepa
- Criterio de arranque

Esta página está dedicada a profundizar cómo producimos: desde genética y cultivo controlado, hasta tinturas, pulverizados, fórmulas herbales y tinturas de hierba única.
En FungiFlora la calidad se define por método, control de variables y capacidad de repetir resultados.
Por eso trabajamos con un sistema interno documentado que conecta cultivo, procesamiento y producto final bajo una misma lógica de trazabilidad.
Cada paso tiene controles específicos. En escritorio se presenta en formato alternado para seguir el recorrido visual de izquierda a derecha.
Paso 01
Cada ciclo inicia con material genético identificado y trazable. No abrimos lotes sin origen documentado ni criterios técnicos de arranque.

Paso 02
El agua es la base del medio de cultivo: controlamos su pH para que el micelio absorba nutrientes eficientemente, la conductividad para verificar la concentración mineral del sustrato, y su limpieza para prevenir contaminación desde el origen. Los tres parámetros se verifican en cada ciclo de producción.
Paso 03
Trabajamos con materias primas de procedencia conocida, esterilización de sustratos y manipulación en ambiente controlado por flujo laminar.

Paso 04
Monitoreamos temperatura, humedad y ventilación con bitácora periódica durante incubación y fructificación para sostener repetibilidad.

Paso 05
Cosechamos en ventana técnica definida para mantener consistencia de perfil entre lotes, evitando sobre y submaduración.

Paso 06
Secado y reducción de partícula bajo parámetros repetibles y condiciones higiénicas documentadas para favorecer biodisponibilidad y estabilidad.

Paso 07
Las tinturas se elaboran con relaciones técnicas fijas y protocolos reproducibles para sostener homogeneidad entre lotes.

Paso 08
Además de hongos, desarrollamos fórmulas herbales y tinturas de hierba única con selección de materia prima, proporciones y registro técnico.

Paso 09
Cada producto final se etiqueta con lote, fecha de elaboración y fecha de vencimiento para vincular etiqueta con historial interno.

Paso 10
Solo los lotes que cumplen checklist completo pasan a disponibilidad comercial. Lo que no cumple estándar, no sale.

Trabajamos distintas presentaciones finales manteniendo la misma disciplina de control y trazabilidad.

Extractos líquidos de especies funcionales como Ganoderma, Cordyceps, Melena de León y Trametes, con trazabilidad de lote.
Ver línea
Presentaciones en polvo para uso flexible, desarrolladas bajo secado y pulverización controlados.
Ver línea
Combinaciones de hongos y plantas para objetivos específicos, con proporciones técnicas definidas.
Ver línea
Extractos de hierbas solas con proceso documentado y control de consistencia por lote.
Ver líneaResumen operativo de variables críticas y registros mínimos antes de liberar producto.
Cambia la forma final del producto y la etapa de procesamiento, pero el control de lote y trazabilidad se mantiene.
Sí. Aunque cambien las materias primas, mantenemos proporciones técnicas, documentación y validación final.
Sí. Si nos compartes el número de lote, te orientamos sobre su etapa y registro de producción.
Si quieres elegir entre tinturas de hongos, pulverizados o fórmulas herbales, te ayudamos según tu objetivo.